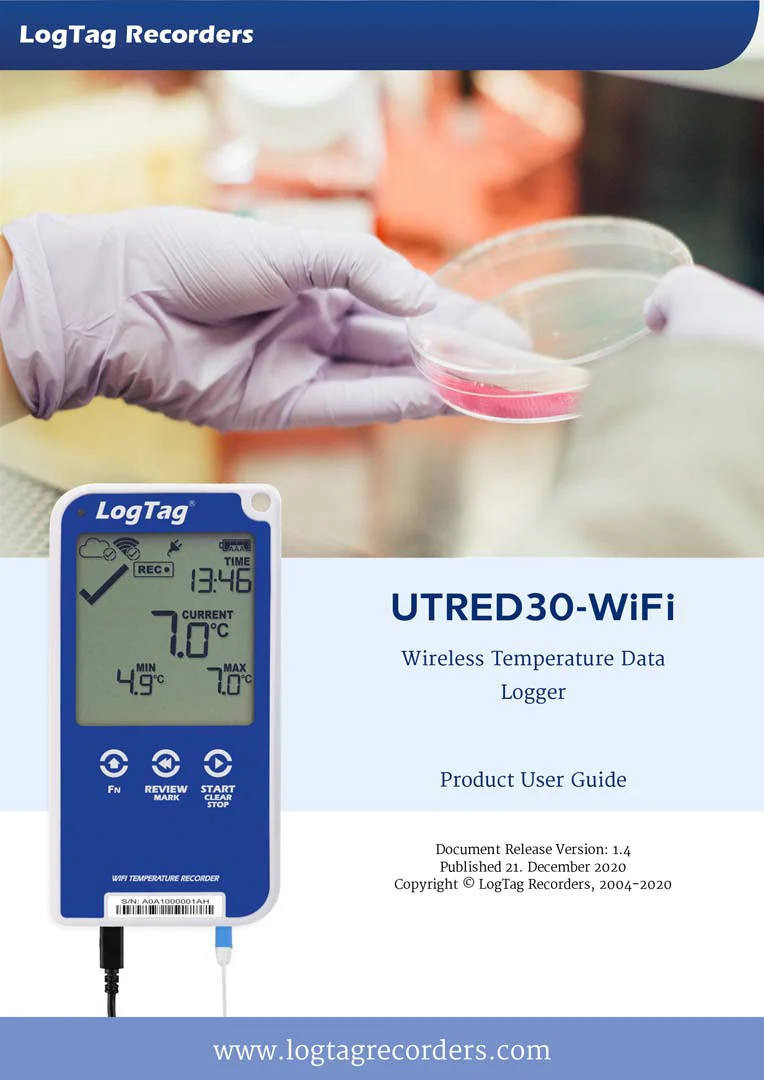

LogTag UTRED30-WiFi Single Channel Temperature Datalogger Kit
- Kit includes: UTRED30-WiFi, ST100K-15 External probe, buffer bottle and wall mount bracket.
- Up to a total of 16,000 temperature readings.
- Reset Min/Max temperature reading at any time.
- Audible alarm & red LED signals a temperature alarm.
- Real-time data automatically uploaded via Wi-Fi to LogTag® Online.
The LogTag® UTRED30-WiFi temperature data logger automatically uploads real-time temperature data to your LogTag® Online cloud account via your existing wireless network.
These include non-volatile memory for up to 16,129 temperature readings and a statistical memory, storing maximum and minimum reading as well as alarm duration for each of the last 30 days in the display.
It features a large, easy-to-read display, along with many familiar attributes known from the LogTag® family of data loggers.